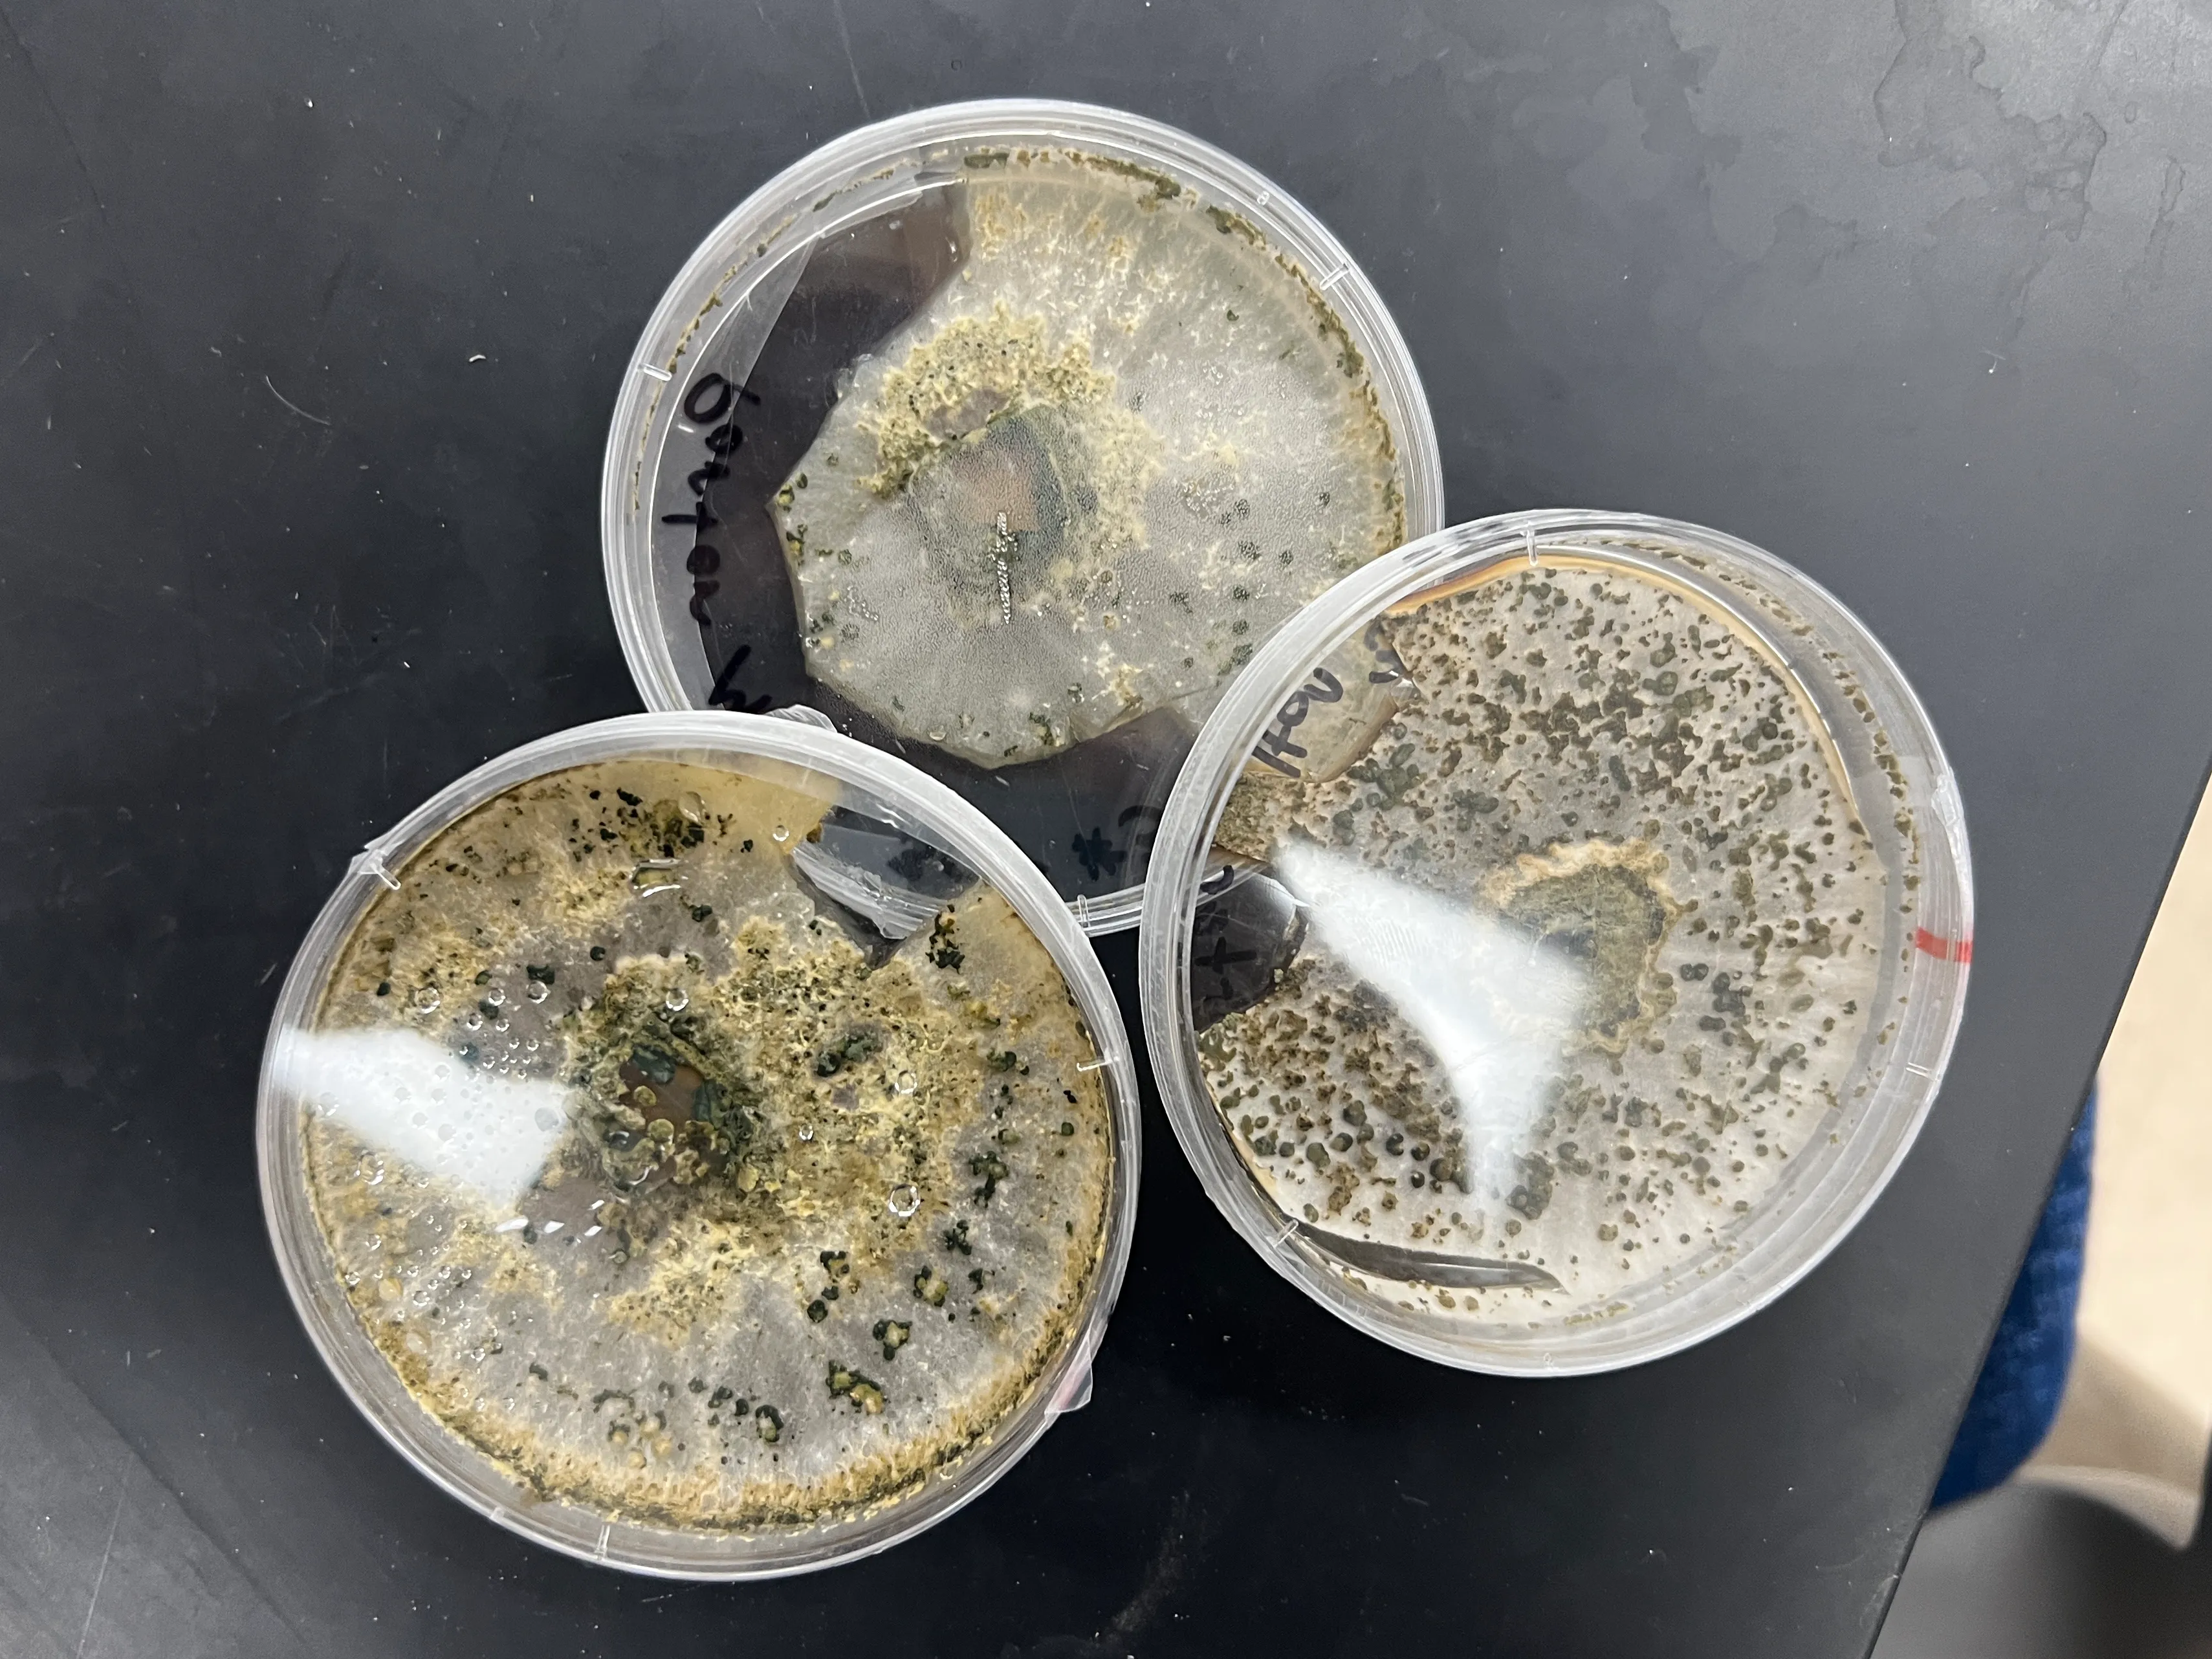
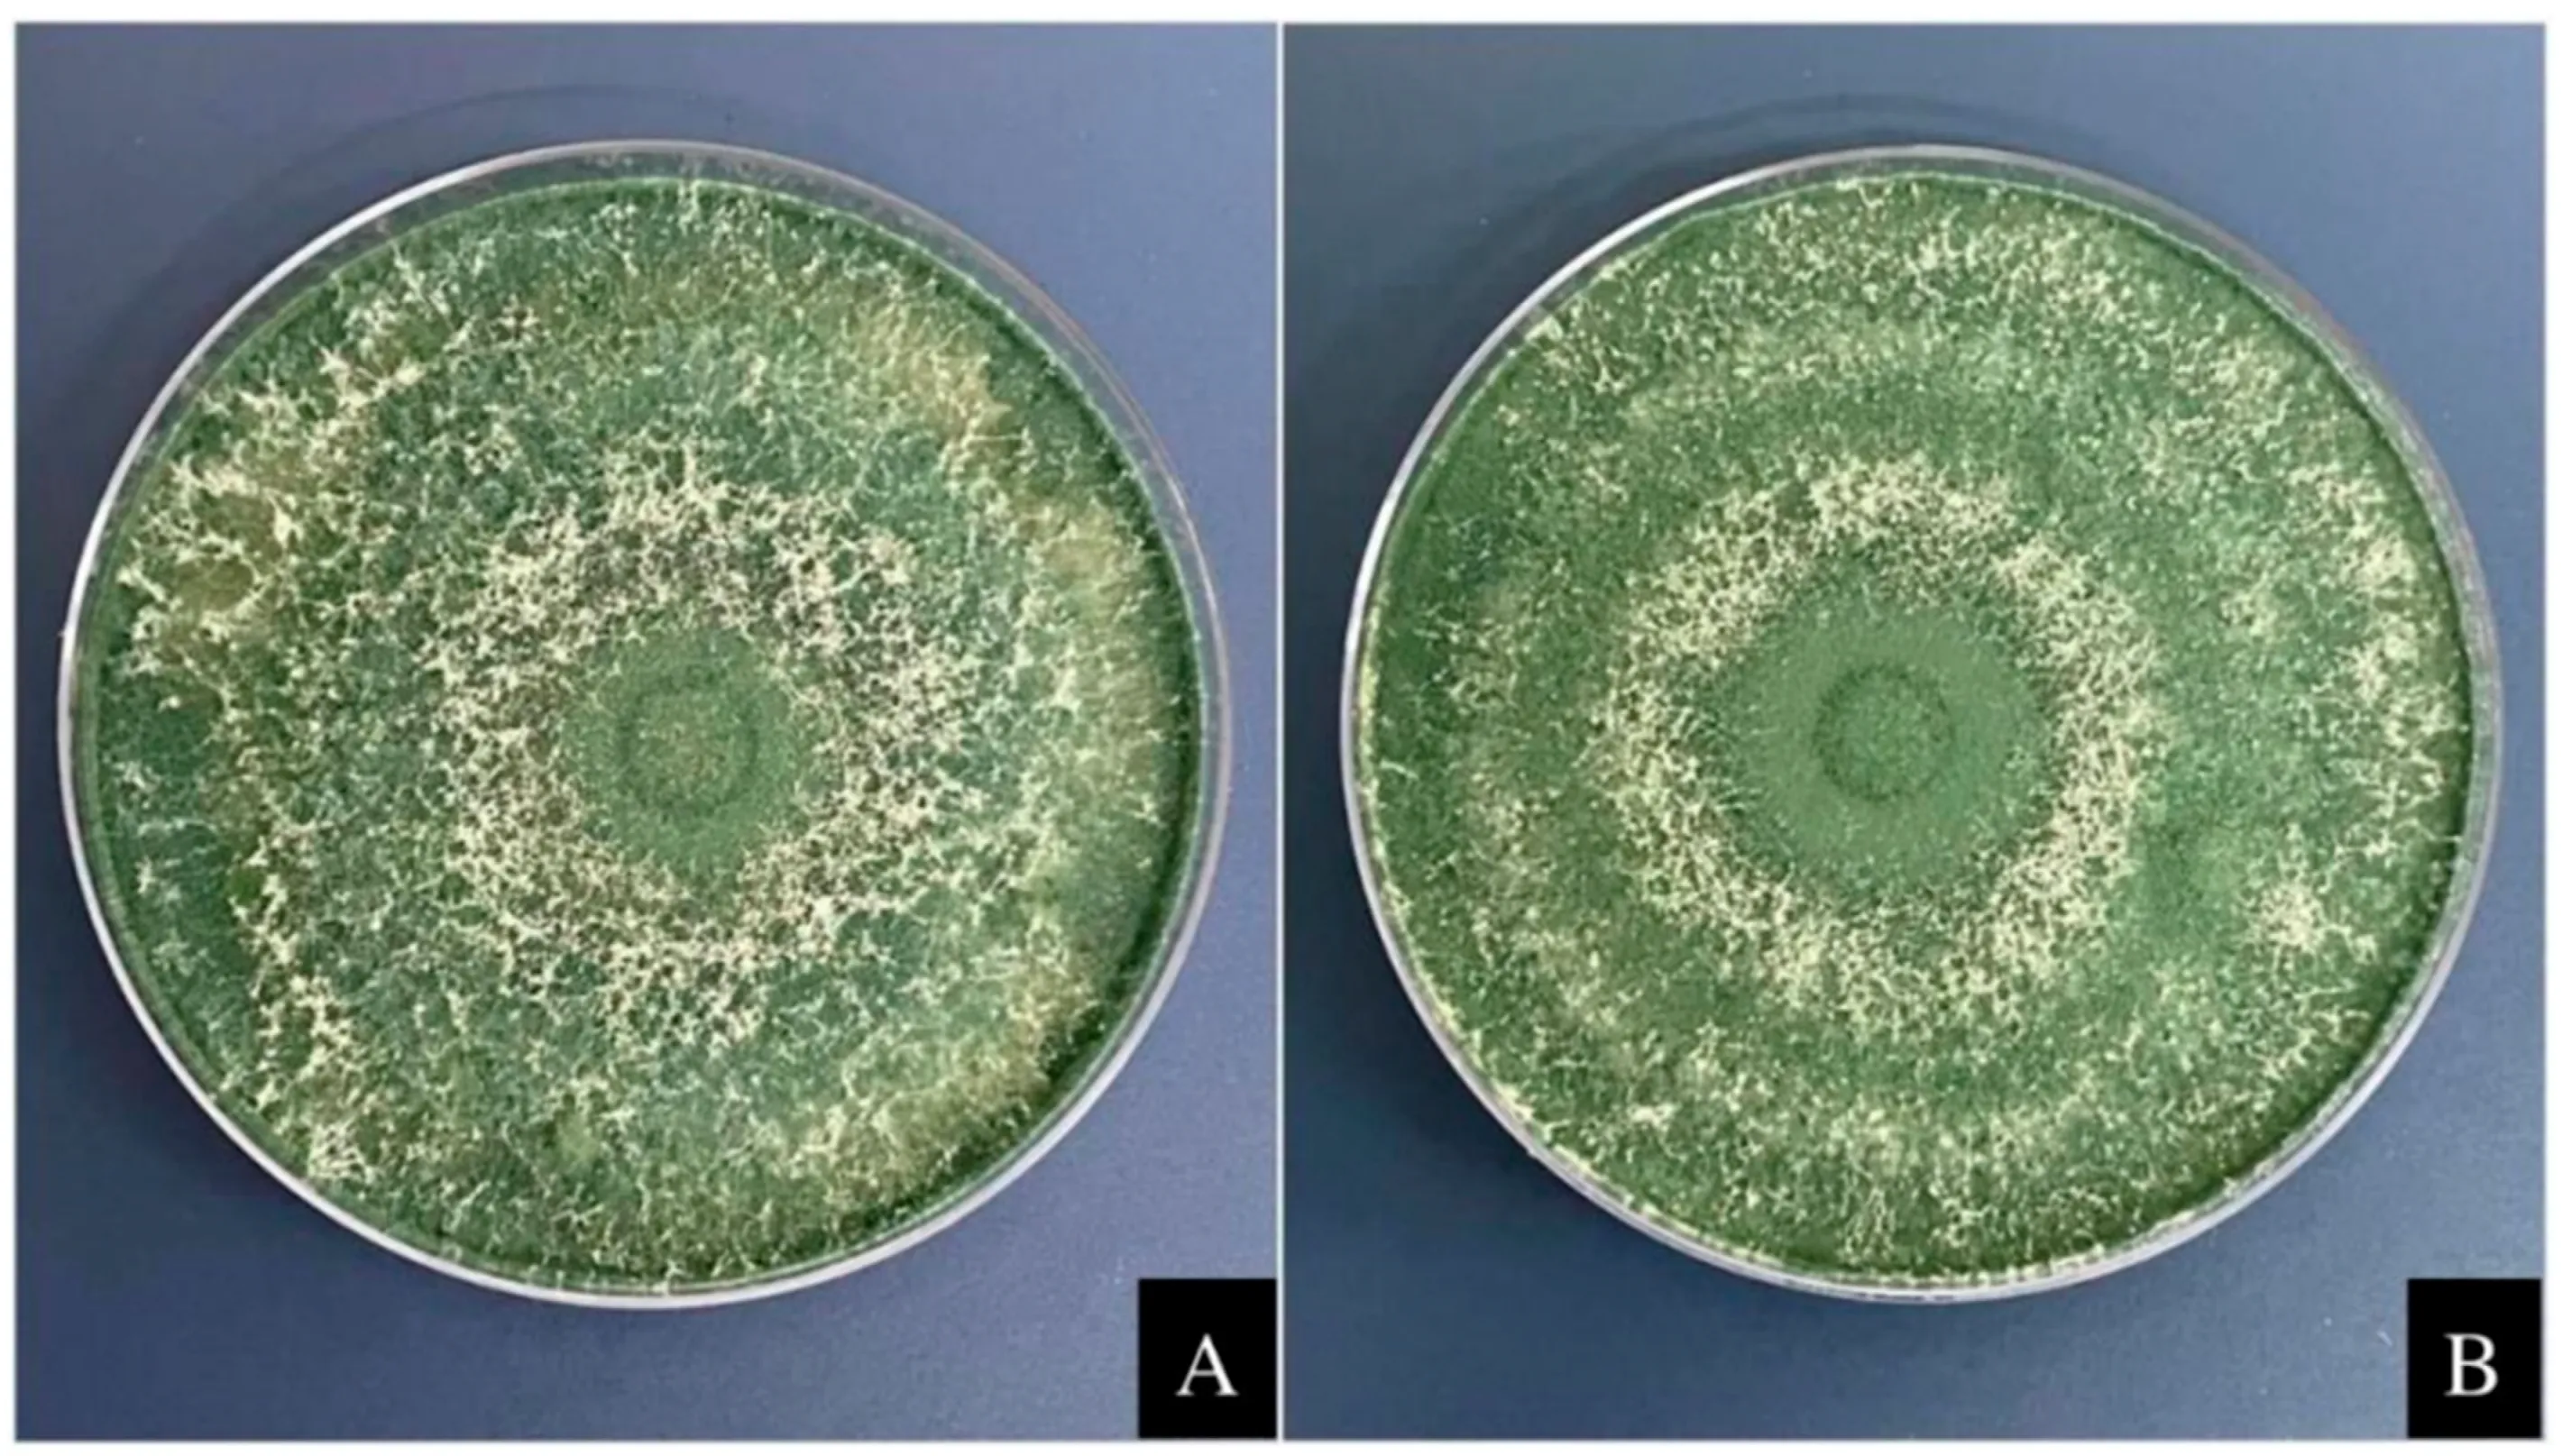

Trichoderma harzianum
In PLPATH123, my pet microbe was Trichoderma harzianum
Trichoderma harzianum is a filamentous fungi found most often in soil and plant root environments. Outside the lab, it is recognized for its biocontrol properties and plant growth promotion. T. harzianum can outcompete harmful microbes without the need for traditional fungicides, similar to how Bacillus thuringiensis can keep plants safe from pests without the need for pesticides.
T. harzianum is also used in environmental and sustainability fields. It can degrade pollutants like pesticides and heavy metals from soils and water, making it really useful for soil resteration and bioremediation. By improving soil health and overall fertility, T. harzianum contributes to increased carbon sequestration, slowing global warming.
In my experiments, I wanted to find the ideal conditions for growing T. harzianum and see if it could fend off the competition from Sclerotinia sclerotiorum, a common pathogen in soybean plants. Growing my microbe was easy, usually on a week-by-week basis, I would take a sample from an old petri dish and place it in a new one (PDA). This would allow the microbe to continue to grow by adding fresh nutrients.
(scroll down)
My pet microbe(s)
My pet microbe(s)
Over the course of a few weeks, I performed 3 experiments to get to know my microbe better.
Experiment #1
In which temperature climate does T. harzianum grow best?
I created 6 petri’s in three environments and recorded which one had the most radial growth.
Experiment #2
When placed in a petri with Sclerotinia sclerotiorum, is T. harzianum able to fend off the competition?
Experiment #3
When inoculated into a soybean plant, can T. harzianum prevent Sclerotinia sclerotiorum from killing the host?
Image of an awesome Trichoderma harzianum (Silva et al.)
Image of an awesome Trichoderma harzianum (Silva et al.)
Peer Experiment
Together with Nina, we brainstormed ideas for her experiment. For ensuring consistent results, we decided to use PDA plates in her humidity experiments. In her experiment, she found that low humidity levels were the best for Fusarium graminearum growth. We didn’t have the same microbe in the project, so I can’t compare results though.